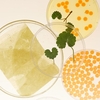
Heveblue Salmon Caring Centella Green Mask Pack

Purchase S$70.00 more to enjoy free shipping.
Brands
Abib
Anua
Arencia
Arocell
Aromatica
Avene
AXIS-Y
Beauty of Joseon
belif
Benton
Be The Skin
Biodance
Bioderma
B:Lab
Braun
Burt's Bees
Celimax
CeraVe
ClearDea
CosRX
CP-1
D'AMU
dear, klairs
DONG-A-PHARM
Dr.Althea
Dr.Ceuracle
Dr.FORHAIR
Dr.Groot
Dr.Jart+
Dr.Nineteen
EYECANDY
Fanola
Florihana
FRANKLY
Fully
Goodal
Growus
Haruharu Wonder
Heimish
Hetras
Heveblue
I'm From
Innisfree
ISNTREE
iUNIK
Jumiso
Kaja
KEYTH
KOPHER
K-SECRET
LAGOM
Laneige
La Roche-Posay
Lindsay
L'Occitane
Make P:rem
Mamonde
Mary & May
Medicube
Mediheal
Melixir
MENOKIN
Mixsoon
Moroccanoil
Mustela
Nature Republic
Needly
Neogen
Nesh
Nineless
Numbuzin
Nutseline
Olaplex
OSiS+
PanOxyl
PHARMACIAN
Phyto
Pleuvoir
Purcell
Purito Seoul
Pyunkang Yul
REJURAN
Rene Furterer
Rom&nd
Round Lab
Sebamed
Secret Key
Shaishaishai
Skin1004
Skinfood
Slowpure
S.Nature
Sulwhasoo
The Face Shop
The Ordinary
TheraBreath
Tirtir
Tocobo
Torriden
UNOVE
Vanicream
Vitafusion
VT Cosmetics
Categories